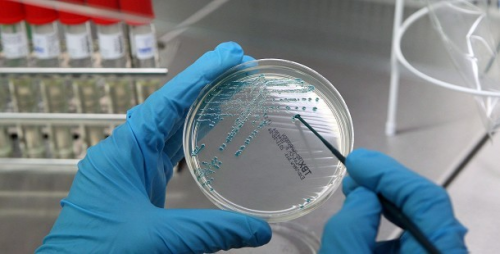

Nagy valószínűség szerint calicivírus-fertőzés áll a budakalászi idősotthonban történt megbetegedések hátterében - erről Szentes Tamás, az országos tisztifőorvosi feladatokért felelős helyettes államtitkár beszélt egy más témában tartott sajtótájékoztatón pénteken Budapesten.
Budapest Főváros Kormányhivatala csütörtökön közölte, hogy a Szentendrei Járási Hivatal és a kormányhivatal azonnali hatállyal vizsgálatot indított a budakalászi Napvirág Idősek Otthonában, ahol a napokban három idős ember meghalt és további hét megbetegedett.Közölték: az Országos Mentőszolgálat bejelentése nyomán a két hivatal népegészségügyi szakemberei haladéktalanul megkezdték a járványügyi és élelmezés-egészségügyi vizsgálatot a budakalászi idősotthonban észlelt hányásos, hasmenéses megbetegedések miatt. A további megbetegedések megelőzése érdekében a többi között szigorított fertőtlenítést rendeltek el.
A betegeket kórházba szállították, a székletminták, az élelmiszer- és ételminták, a tisztasági minták begyűjtése megtörtént, laboratóriumi vizsgálatuk zajlik - fűzték hozzá.Lipterné Bierbaum Erika, az intézmény vezetője az otthon honlapján csütörtökön azt közölte, hogy a működés felügyeletét végző hatóságok által indított vizsgálatok még zajlanak, ezek befejezéséig nem kívánnak nyilatkozni.
Hozzátette: az intézmény a működése során a szakmai protokollok szerint jár el, vagyis folyamatosan fokozott figyelmet fordítanak az idősek gondozására, a korukra és betegségeikre tekintettel."Jelen helyzet, valamint a tisztiorvosi szolgálat által kiadott hőségriasztás ésszerű kezeléséhez szükséges valamennyi intézkedést megtettük és folyamatosan meg is tesszük. Az intézmény működése - valamennyi területen - az eseményektől függetlenül folyamatos" - fogalmazott a közleményben a vezető.
Forrás: MTI